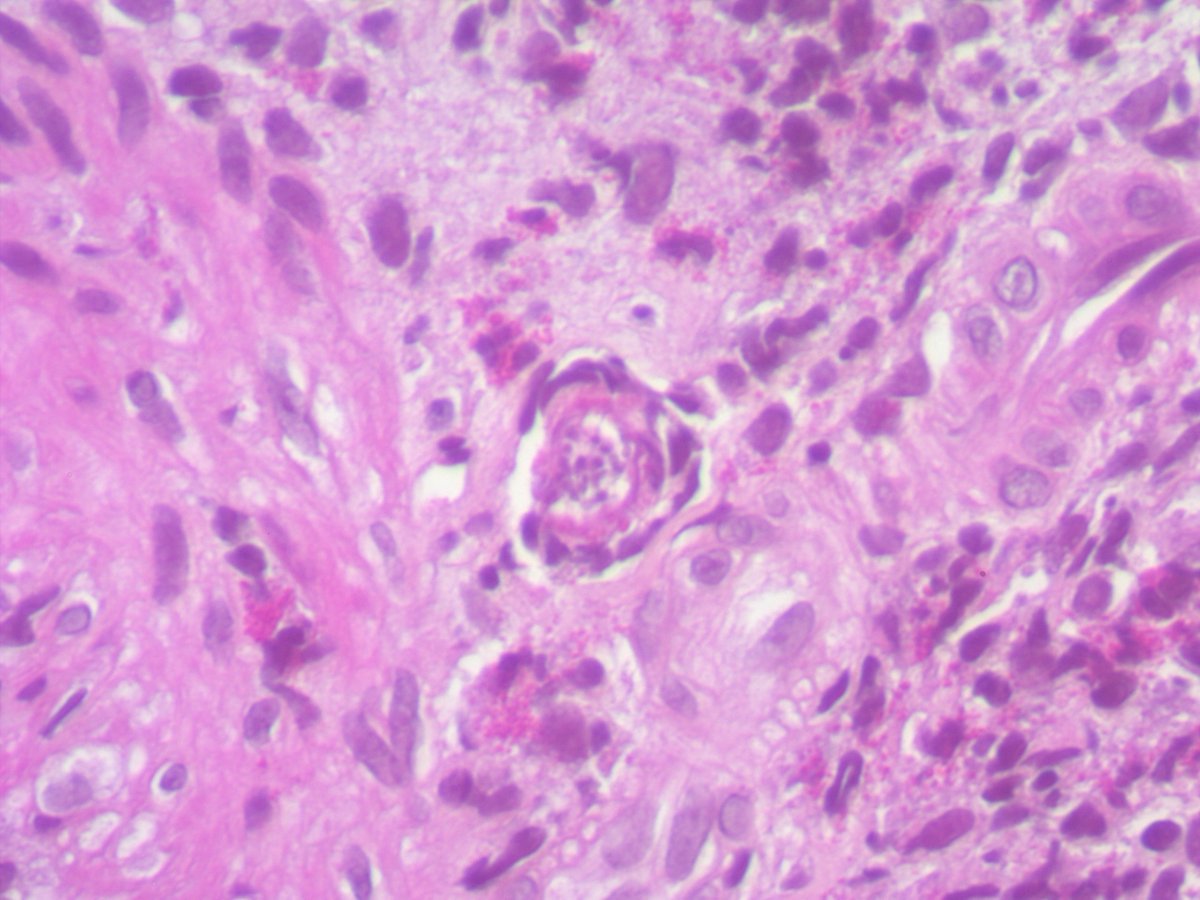
Celina Stayerman MD tweet media
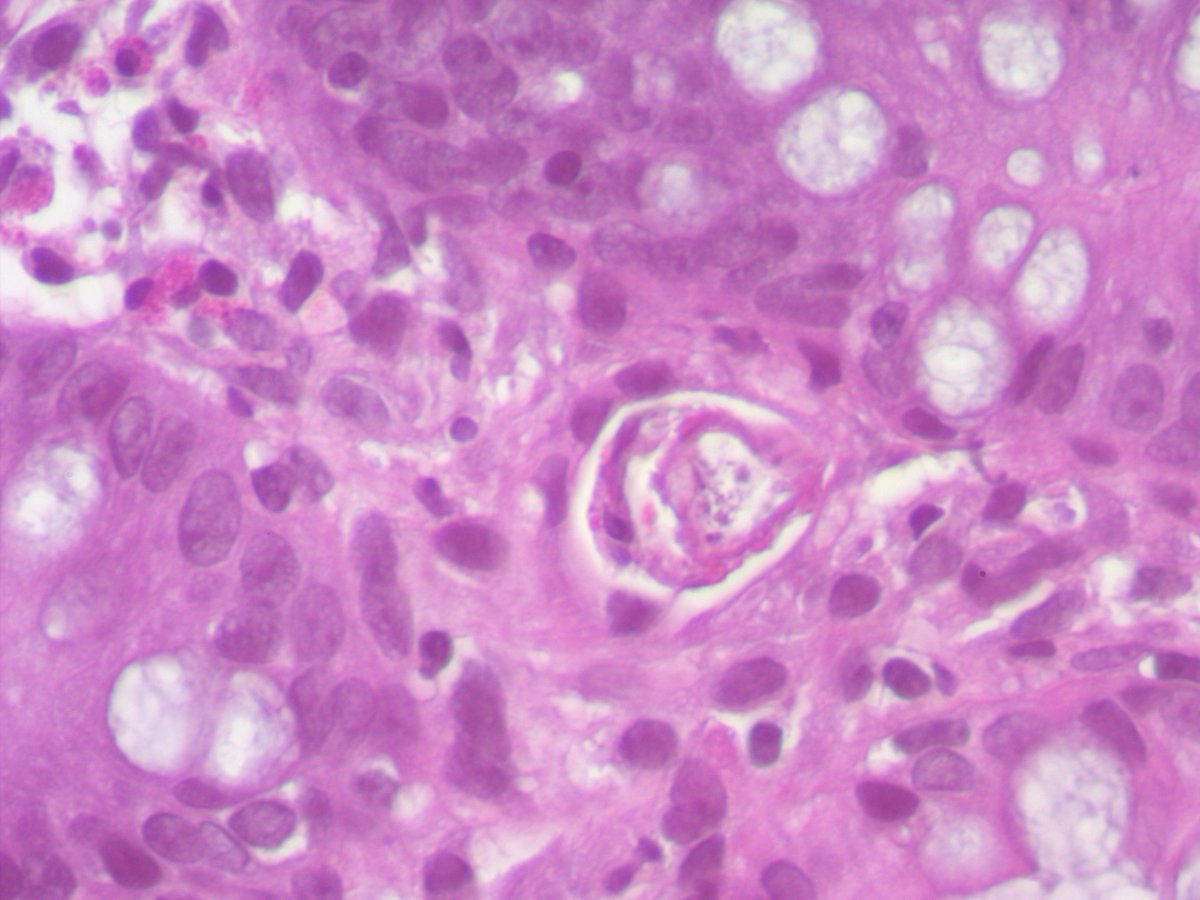
Celina Stayerman MD tweet media
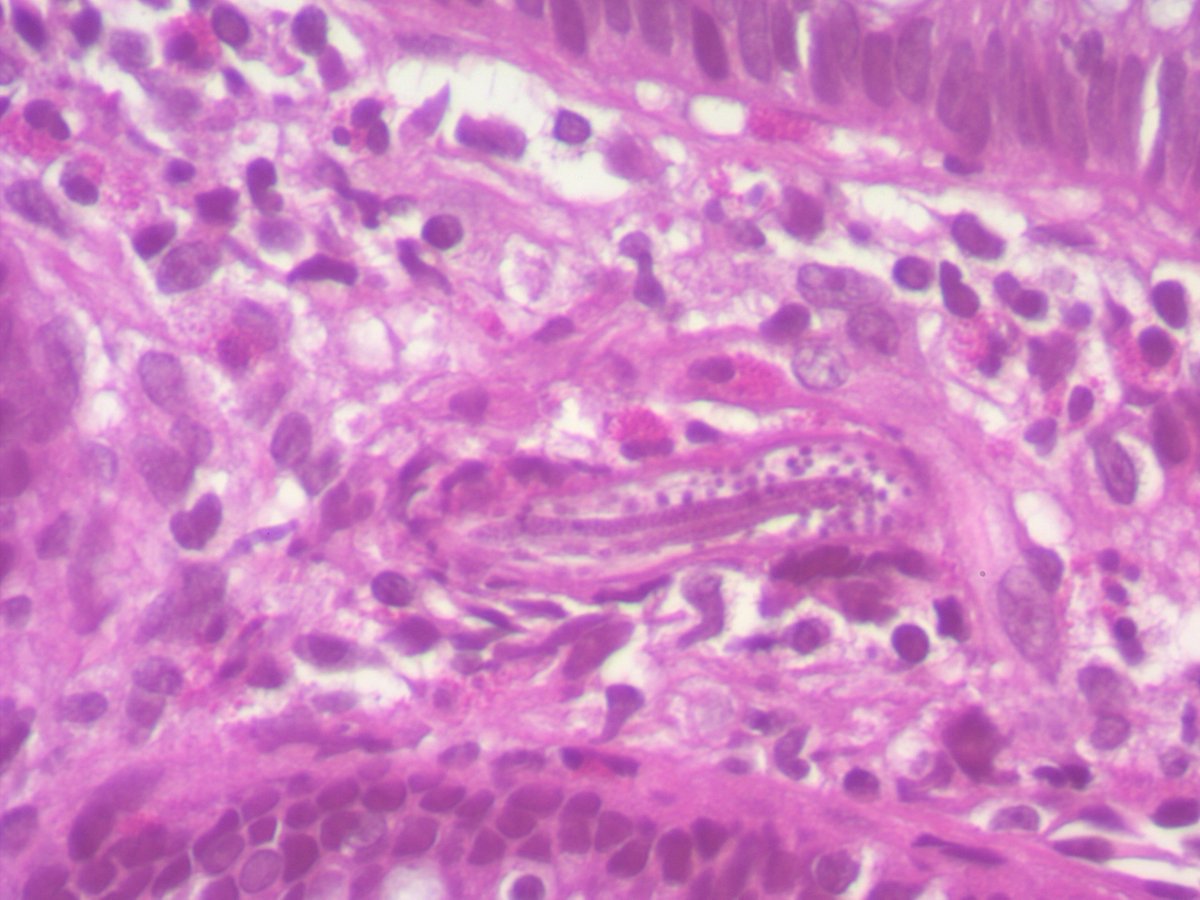
Celina Stayerman MD tweet media

Michael Feely, DO retweetledi

Interested in the crossroads of pediatric and adult GI pathology? Members can join us today at 12:00 PM EST for a free e-Learning forum. Please see the details below! #GIPS #GIpath #pathology

English
Michael Feely, DO
458 posts


@MFeelyDO
Gastrointestinal and Liver Pathologist at University of Florida

UF has the highest 1y liver graft survival in US. HR of graft loss is 75% lower than the American average. Heavy work by many people and reason of great honor for us. Could not be prouder of the team! Gators strong! 🐊@UF @UFHealth @UFSurgery @ASTSChimera #livertwitter




Any thoughts on this beautiful, elegant creature that "crawled" into the colonic mucosa and presented as polyp !! I have been googling it for ages and can't find a morphologic fit with any of the adult/ larval parasitic forms that I have ever encountered. Pt is asymptomatic.




